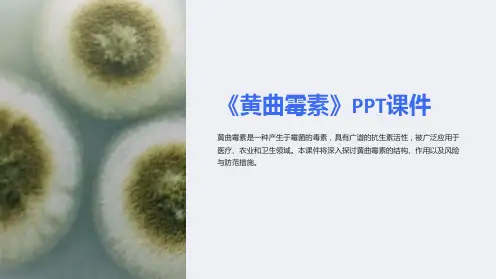

2019
-
18
2019
-
6
该毒素的靶器官是肝脏,因而属肝
脏毒,可引起碱性磷酸酶、转氨酶、异柠
檬酸脱氢酶活性升高,肝脂肪增多,肝糖
原下降以及肝细胞变性、坏死。此外,黄
曲霉毒素还具有致癌、致突变和致畸性,
可使畜禽、人、实验动物诱发肝癌、胃
腺癌、肾癌、直肠癌、乳腺瘤、卵巢瘤
和皮下肉瘤等。黄曲霉毒素是已发现毒
素中最强的致癌物, 如AFTB1诱发肝癌的
%~8%石灰水浸泡霉败饲料3~5h后,再用清
水淘净,晒干便可饲喂;每千克饲料拌入12.5g
的农用氨水,混匀后倒入缸内,封口3~5d,去毒
效果达90%以上,饲喂前应挥发去残余的氨气;
还可用0.1%漂白粉水溶液浸泡处理等。
物理吸附法:常用的吸附剂为活性炭、白 陶土、粘土、高岭土、沸石等,特别是沸石可 牢固地吸附黄曲霉毒素, 雏鸡和猪饲料中添加 0.5%沸石,不仅能吸附毒素, 而且还可促进生
本病于20世纪50年代在英国苏格兰发生,当 时称为“火鸡X病”,相继在美国、巴西和南 非等18个国家发生。我国长江沿岸及其以南地 区的饲料污染黄曲霉毒素较为严重,而华北、 东北及西北地区的饲料污染黄曲霉毒素则相对 较少。
2019
-
2
各种畜禽均可发生本病,但由于性
别、年龄及营养状况的不同,其敏感性
也有差别。一般地说,幼年动物比成年 动物敏感,雄性动物比雌性动物(怀孕
诊断对黄曲霉毒素中毒的诊断应从病史调查入手并对饲料样品进行检查结合临床表现黄疸出血水肿消化障碍及神经症状和病理学变化肝细胞变性坏死肝细胞增生肝癌等情况可进行初步诊断
霉菌毒素中毒
霉菌在自然界中分布极广,种类繁多。目前有记载 的约达35 000种以上。其中绝大多数是非致病性霉菌, 有些已被用于酿造业、制药工业等。只有少数霉菌在 基质(饲料)上生长繁殖过程中产生有毒代谢产物或次 生代谢产物,称为霉菌毒素。